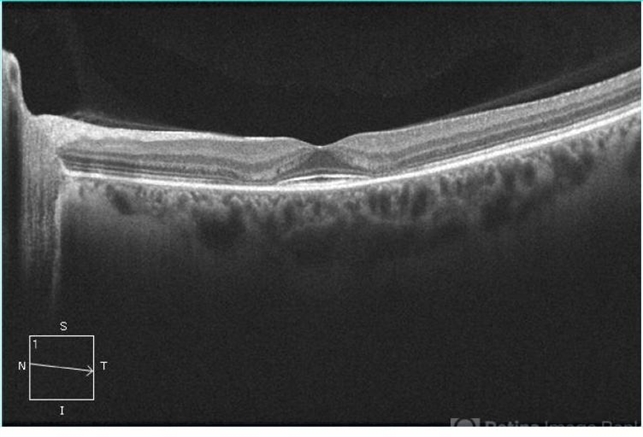
file

-
By Theodore Leng, MD, MS, FASRS
Byers Eye Institute at Stanford University School of Medicine - Uploaded on Apr 30, 2013.
- Last modified by Theodore Leng, MD, MS, FASRS on Apr 30, 2013.
- Rating
- Appears in
- Plaquenil Toxicity
- Condition/keywords
- plaquenil toxicity, hydroxychloroquine toxicity
- Imaging device
- Optical coherence tomography system
- Description
- SD-OCT scan from a 44-year-old woman with bilateral plaquenil toxicity. There is damage visible in the outer retina in a perifoveal distribution.

Initializing download.
Initializing download.


